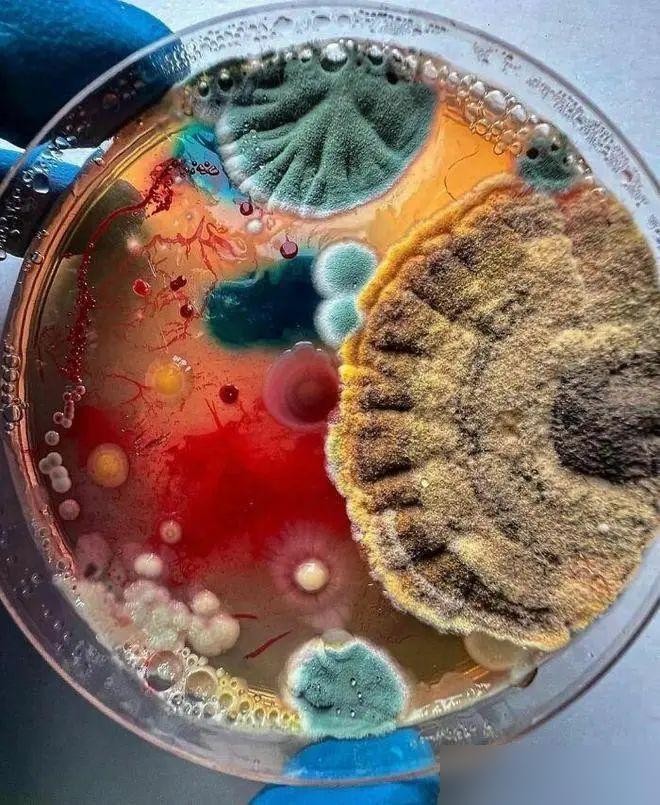

25种大自然中的奇异发现:充满了不可思议的奇迹和壮丽的景观。
导语
大自然是一个神奇的地方,充满了不可思议的奇迹和壮丽的景观。
在这片广袤无垠的土地上,我们时常能够发现一些令人惊叹的奇特现象和物体,它们或是自然形成的奇迹,或是生命的杰作,展现出大自然的无穷创造力和神秘魅力。

本文将带您领略25种大自然中不寻常的现象和物体,每一个都让人惊叹连连,感受到大自然的力量与美丽。
这些奇异发现将通过生动的描述和精美的图片向您展示大自然的奥妙之处,让您不禁惊讶于大自然的鬼斧神工。
自然奇迹。
1.熔岩天窗。
在夏威夷,大自然的力量展现得淋漓尽致,一条熔岩流倾泻进一个名为熔岩天窗的空洞中,形成了这幅壮观的景象。
熔岩天窗是熔岩流在地下经过一段时间后,表层冷却凝固,内部仍处于高温状态,最终形成了一个中空的隧道,当熔岩流经过时,就会形成熔岩喷发的壮观场面。

2.墨西哥巨型仙人掌。
墨西哥的沙漠中生长着一种巨型仙人掌,名为卡尔索仙人掌,它们可以长到超过12米的高度,甚至比一栋房子还要高!
这是一种名为“卡尔索”的区域性的仙人掌品种,这种巨型仙人掌不仅惊人地高大,而且生长速度极慢,通常需要数十年才能达到这样的高度。

3.世界上最大的树。
美国加州的红杉国家公园里,有一棵被称为“将军树”的巨型红杉,它是世界上最大的树,高度达到了83.8米,周长达到了31.3米!
将军树不仅是世界上体积最大的树木,也是地球上活得最久的树木之一,年龄超过了3200年。
4.1400岁银杏树。
中国西安的一棵银杏树,被称为“古银杏”,据说有超过1400年的历史,每到秋天,这棵树的叶子都会变成金黄色,吸引大量游客前来观赏。
这棵古老的银杏树不仅是一个旅游景点,更是当地人心中的文化象征,被誉为“生命之道”。
5.海百合化石。
在英国的一条河流中,发现了一块巨大的岩石,上面布满了海百合化石,这些化石记录了大约3亿年前的生命。
海百合是一种古老的海洋生物,与现代的海胆有亲缘关系,它们在地球上生活了数亿年,但在6500万年前灭绝。

奇特植物。
6.葫芦。
这种长得像西瓜一样的植物其实是一种叫做“美国西葫芦”的水果,它们不仅外形奇特,而且味道鲜美,是一种健康的蔬菜。
美国西葫芦是一种幼果,当它们成熟时,会变成深绿色或黄色,并且外形会变得更加圆润。

7.长得像角的番茄。
这种长得像角一样的番茄其实是一种叫做“牛角椒”的辣椒,它们的形状就像牛角一样,非常奇特。
牛角椒是一种常见于南美洲的辣椒品种,因其形状独特而得名。
8.海芋。
这种花朵看起来就像是被染了血一样,其实它叫做“海芋”,是一种名为“阿芙兰”的植物,它们在开花时会释放一种特殊的香味,吸引昆虫来授粉。
海芋不仅外形奇特,而且有毒,不适合食用。

9.魔鬼刺。
这种植物叫做“魔鬼刺”,它是一种名为“刺果龙葵”的植物,它们的果实成熟时会变成鲜红色,非常诱人,但却有毒,不适合食用。
魔鬼刺主要分布在南美洲和北美洲的干旱地区。

10.巨型蝴蝶兰。
这种巨大的兰花叫做“巨型蝴蝶兰”,它是一种名为“贝尔蝴蝶兰”的植物,是世界上最大的兰花品种之一。
巨型蝴蝶兰原产于东南亚地区,其花朵直径可以达到30厘米,非常壮观。
自然调色盘。
11.五彩斑斓的细菌培养皿。
这些五彩斑斓的细菌培养皿看起来就像是大自然的调色盘,实际上它们是由不同种类的细菌在培养皿中繁殖形成的,每种细菌都有自己独特的颜色。
这种现象被称为细菌发酵,是细菌在代谢过程中释放出不同颜色的色素。

12.雪花。
这张雪花照片展示了大自然中最美丽的奇迹之一,每一片雪花都是独一无二的,就像人类的指纹一样。
雪花是水蒸气在寒冷空气中凝结成冰晶后形成的,冰晶会在空中飘落时吸附更多的水蒸气,最终形成美丽的雪花形状。
13.闪电。
这张照片展示了大自然中最壮观的奇迹之一,每一道闪电都是大气中带电粒子之间发生放电反应后形成的。
闪电不仅美丽,还具有强大的能量,每一道闪电释放出的能量足够让一千瓦时的电灯点亮一千个小时!

14.极光。
极光是地球上最美丽的自然现象之一,由太阳风与地球磁场相互作用后产生的光芒。
极光通常出现在极地地区,并且有着多种颜色和形状,是大自然中最神秘和美丽的奇迹之一。
15.火山喷发。
火山喷发是地球内部能量释放的一种方式,当地球内部压力过大时,就会导致岩浆涌出地表,形成火山喷发现象。
火山喷发不仅危险,还能创造出美丽的火山口和熔岩流景观。

令人惊叹的人造奇迹。
16.大堡礁。
大堡礁是世界上最大的珊瑚礁群,位于澳大利亚东北海岸,由超过2900个珊瑚礁构成,是大自然中最美丽和多样化的生态系统之一。
大堡礁不仅美丽,更是世界上生物多样性最高的地方之一,是许多海洋生物的栖息地。

17.长城。
中国的万里长城是人类历史上最伟大的建筑之一,是数代人用汗水和血液建造而成的,被誉为“世界第八大奇迹”。
万里长城不仅壮观,更是中国古代文明的重要象征。

18.金字塔。
埃及的金字塔是世界上最古老的人造建筑之一,是古埃及法老墓葬用来安葬法老和贵族的重要建筑。
金字塔是数千名工匠用巨石建造而成,被誉为“世界七大奇迹”之一。

19.泰姬陵。
印度的泰姬陵是一座宏伟壮丽的大理石陵墓,是穆斯林皇帝沙贾汗为了纪念已故妻子而建造的,被誉为“爱的纪念碑”。
泰姬陵不仅美丽,更是印度穆斯林建筑艺术的巅峰之作,也是世界著名的旅游景点之一。
20.百慕大三角。
百慕大三角是北大西洋中的一个神秘海域,因其在历史上发生过多起船只和飞机离奇失踪事件而闻名于世,被誉为“魔鬼三角洲”。
百慕大三角至今仍然是一个未解之谜,人们对其产生了许多传说和猜测。
结语
大自然永远都是最好的艺术家,在这个奇妙无比的星球上,我们每天都能感受到无穷无尽的新鲜事物,从熔岩流、巨型仙人掌到古老的银杏树,再到海百合化石、奇特植物和五彩斑斓的细菌培养皿,这些都是大自然馈赠给我们的宝贵礼物,让我们在惊叹之余,也对大自然的神奇力量心存敬畏。
大自然是我们生命的源泉,我们应该保护好这个美丽星球上的每一个奇迹,让它们永远与我们同在,让未来的人类也能感受到大自然带来的惊艳与震撼。





















